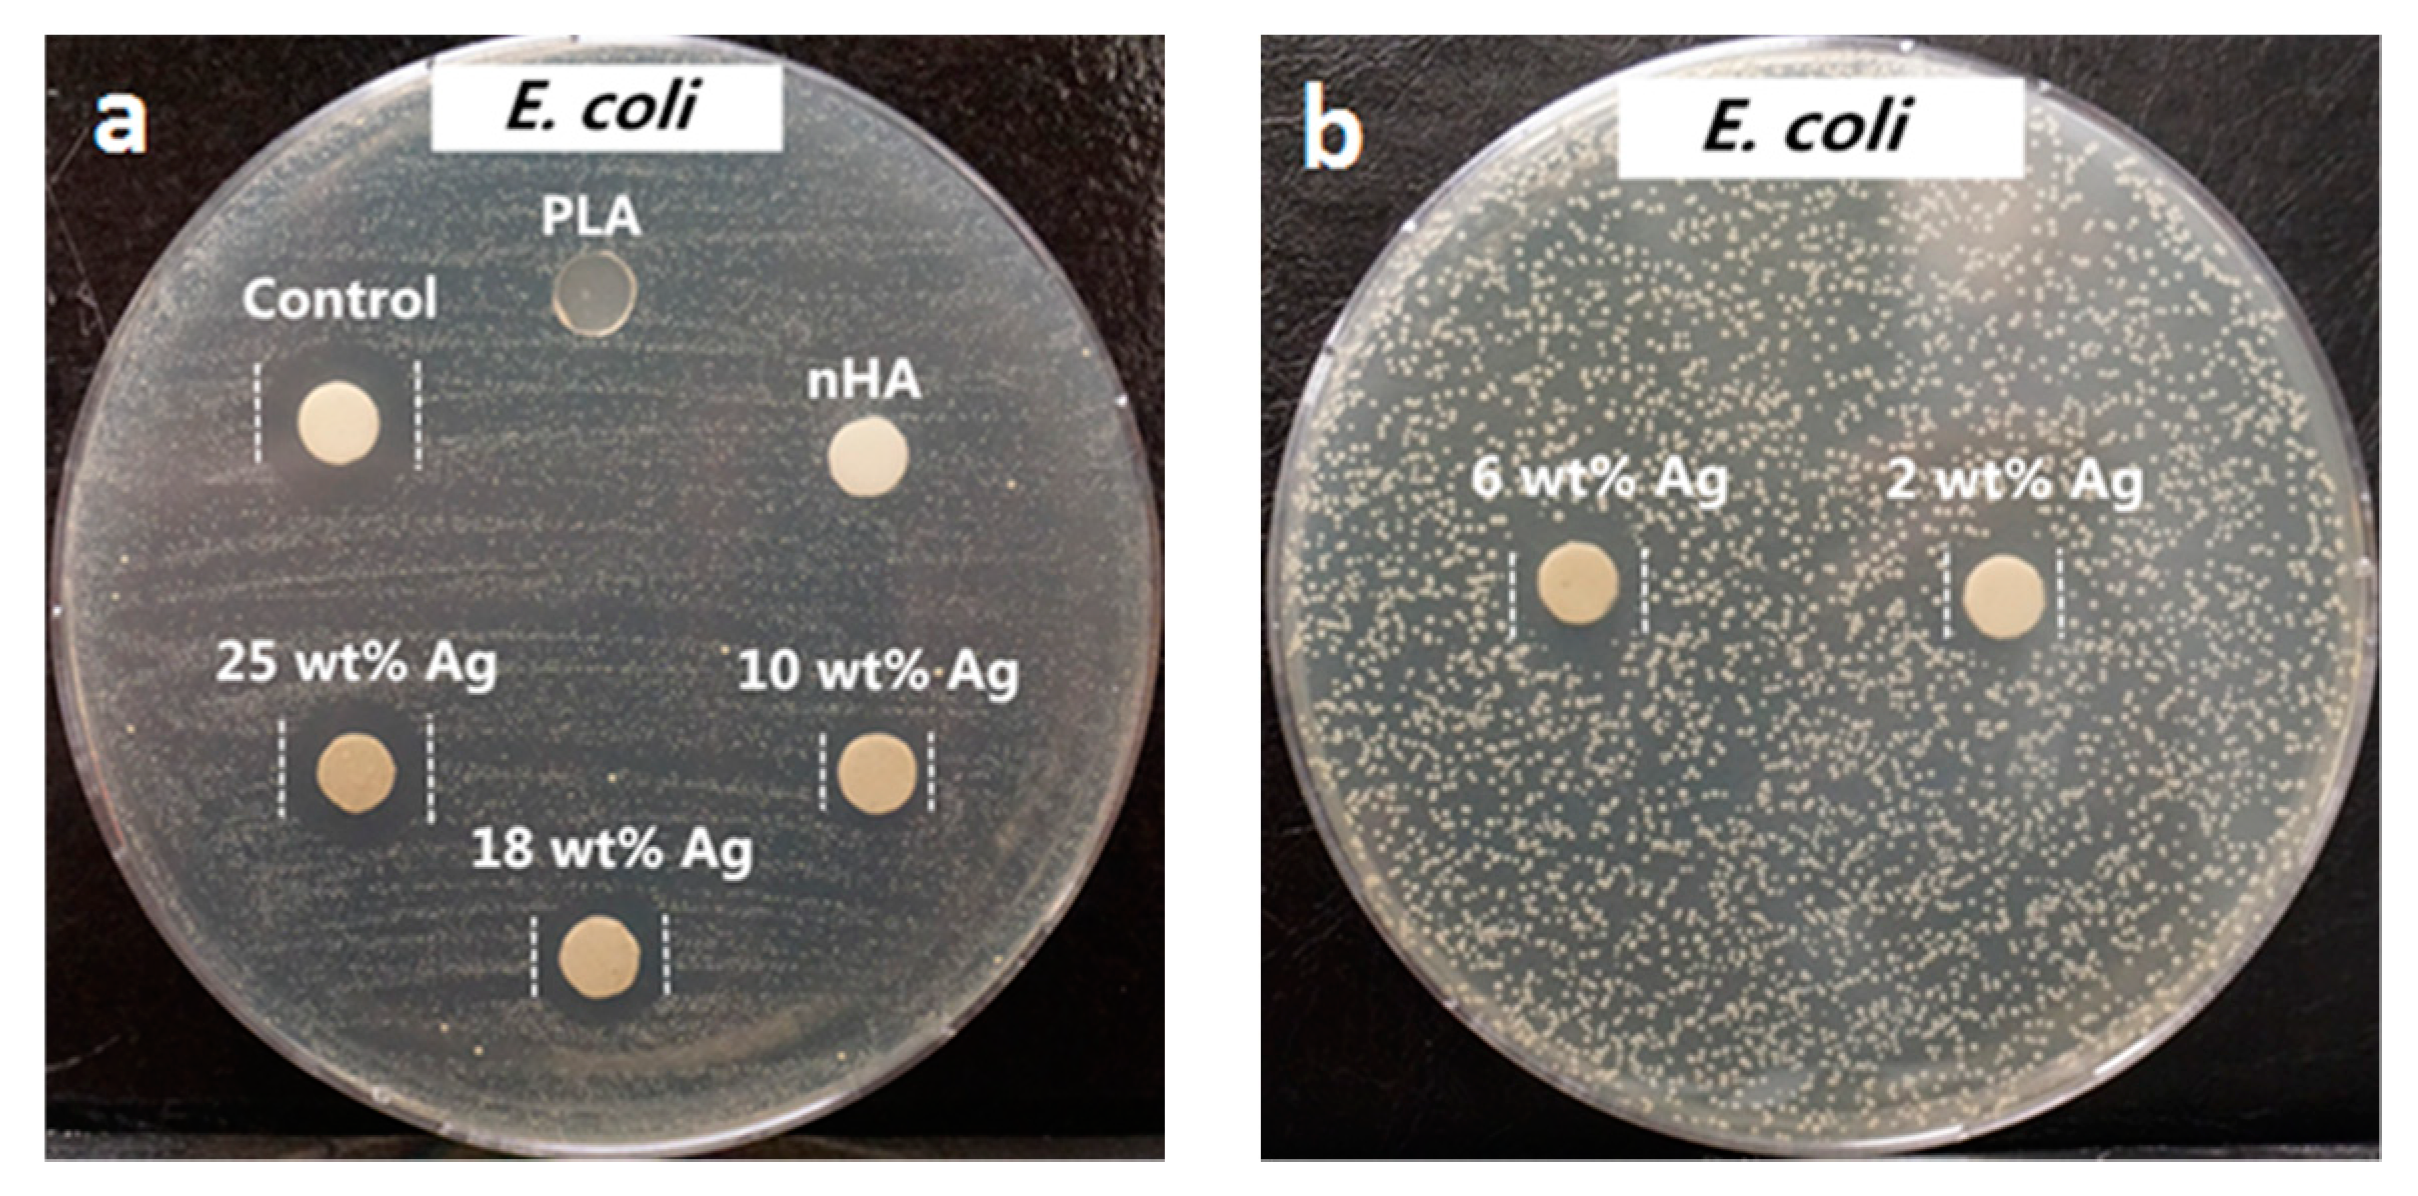
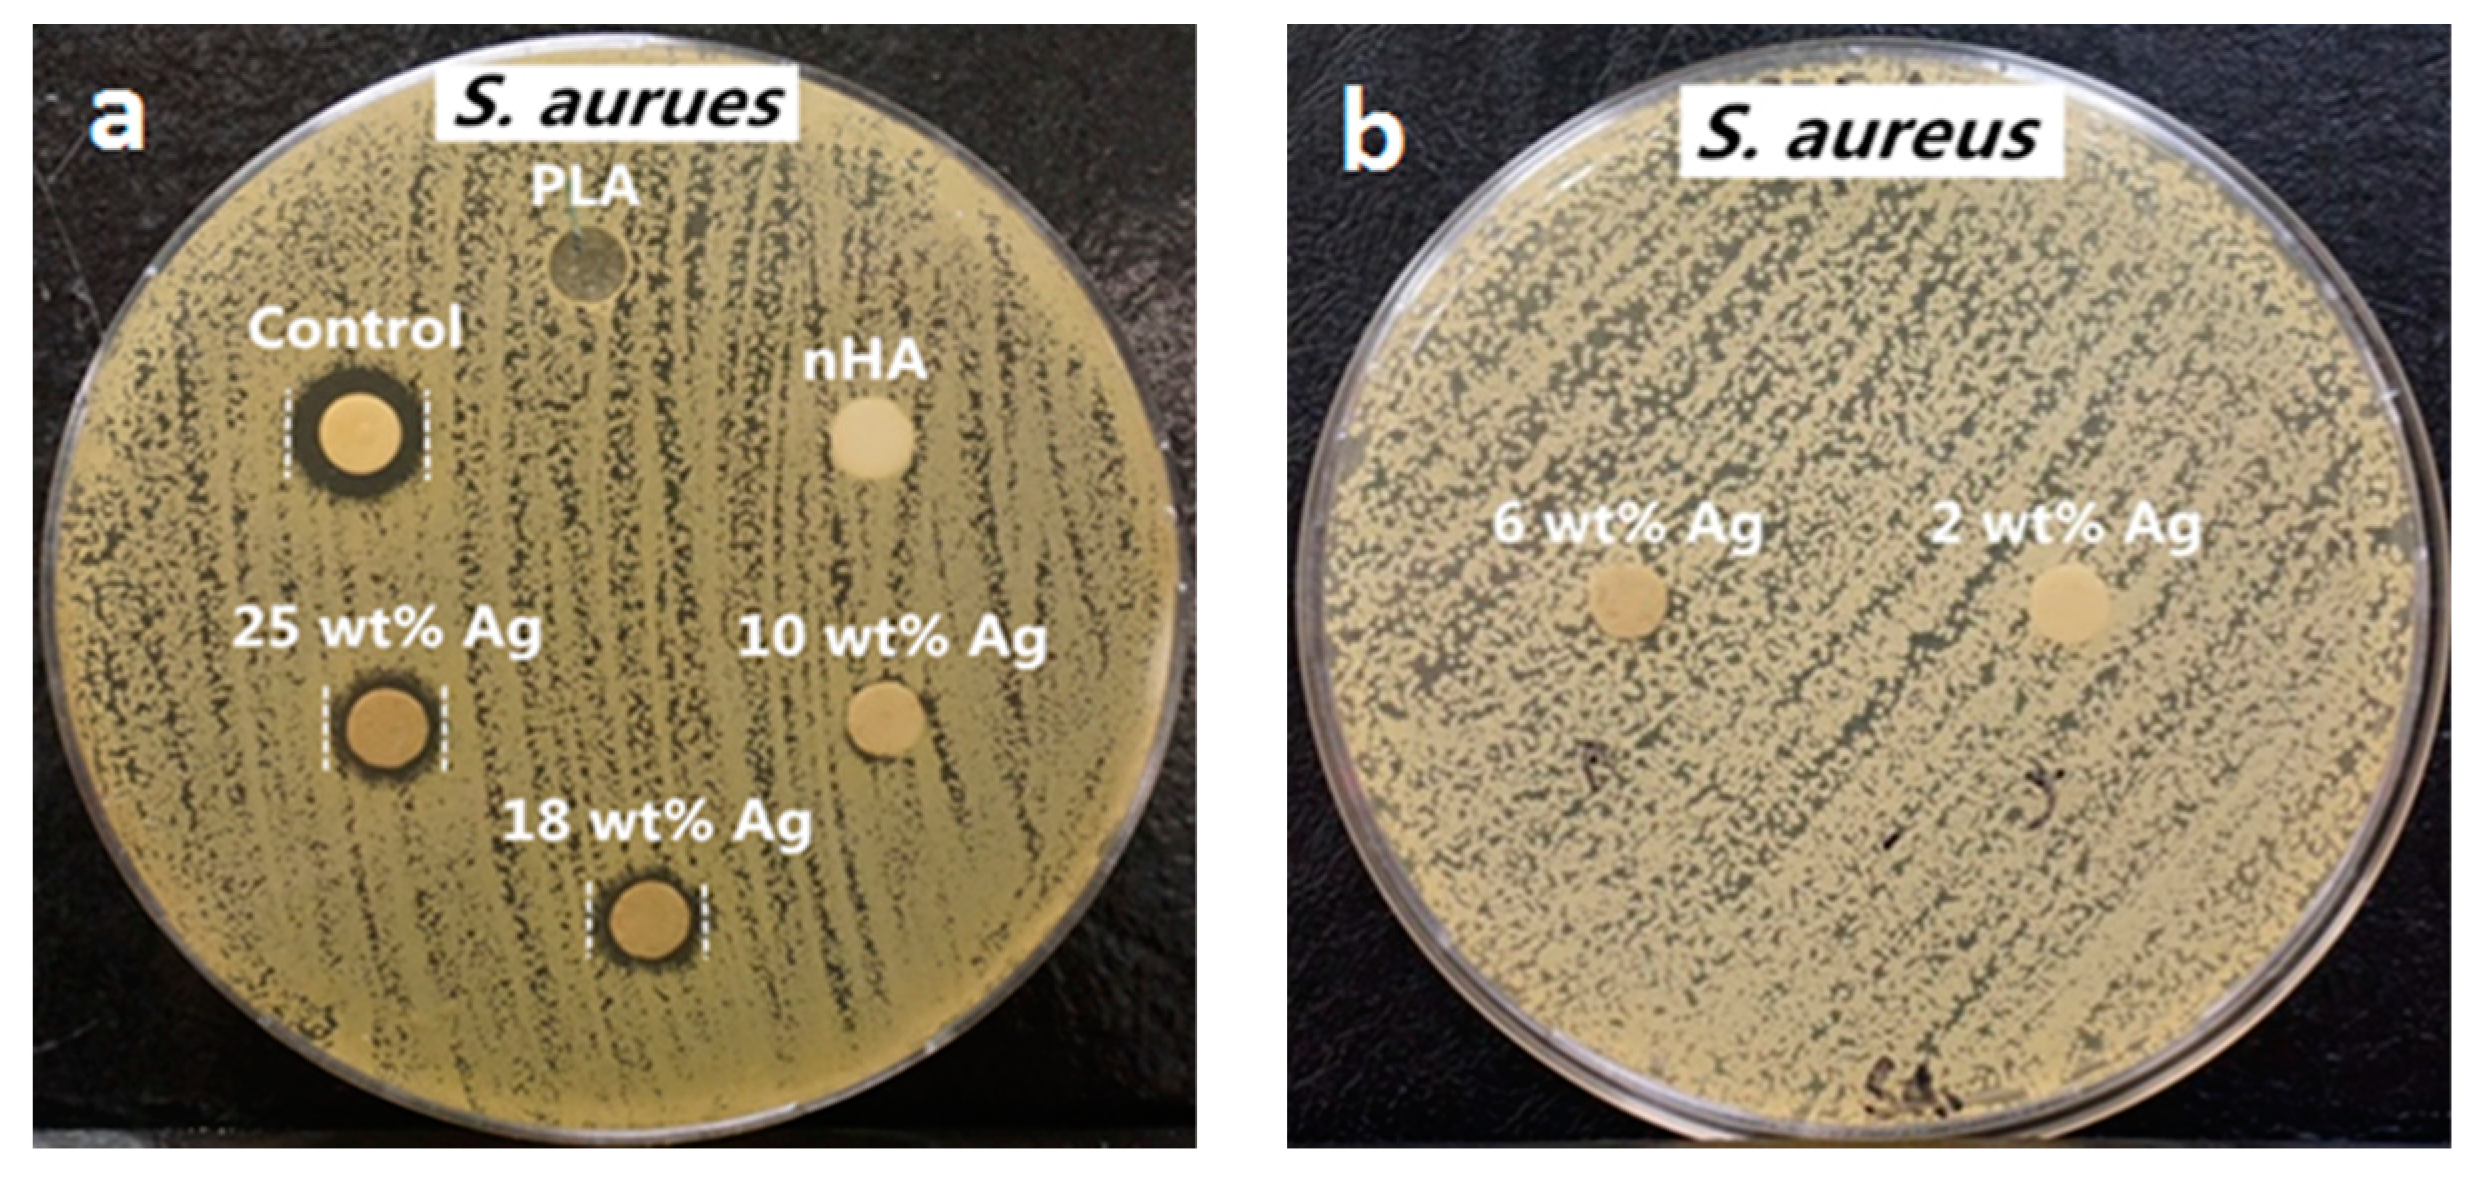
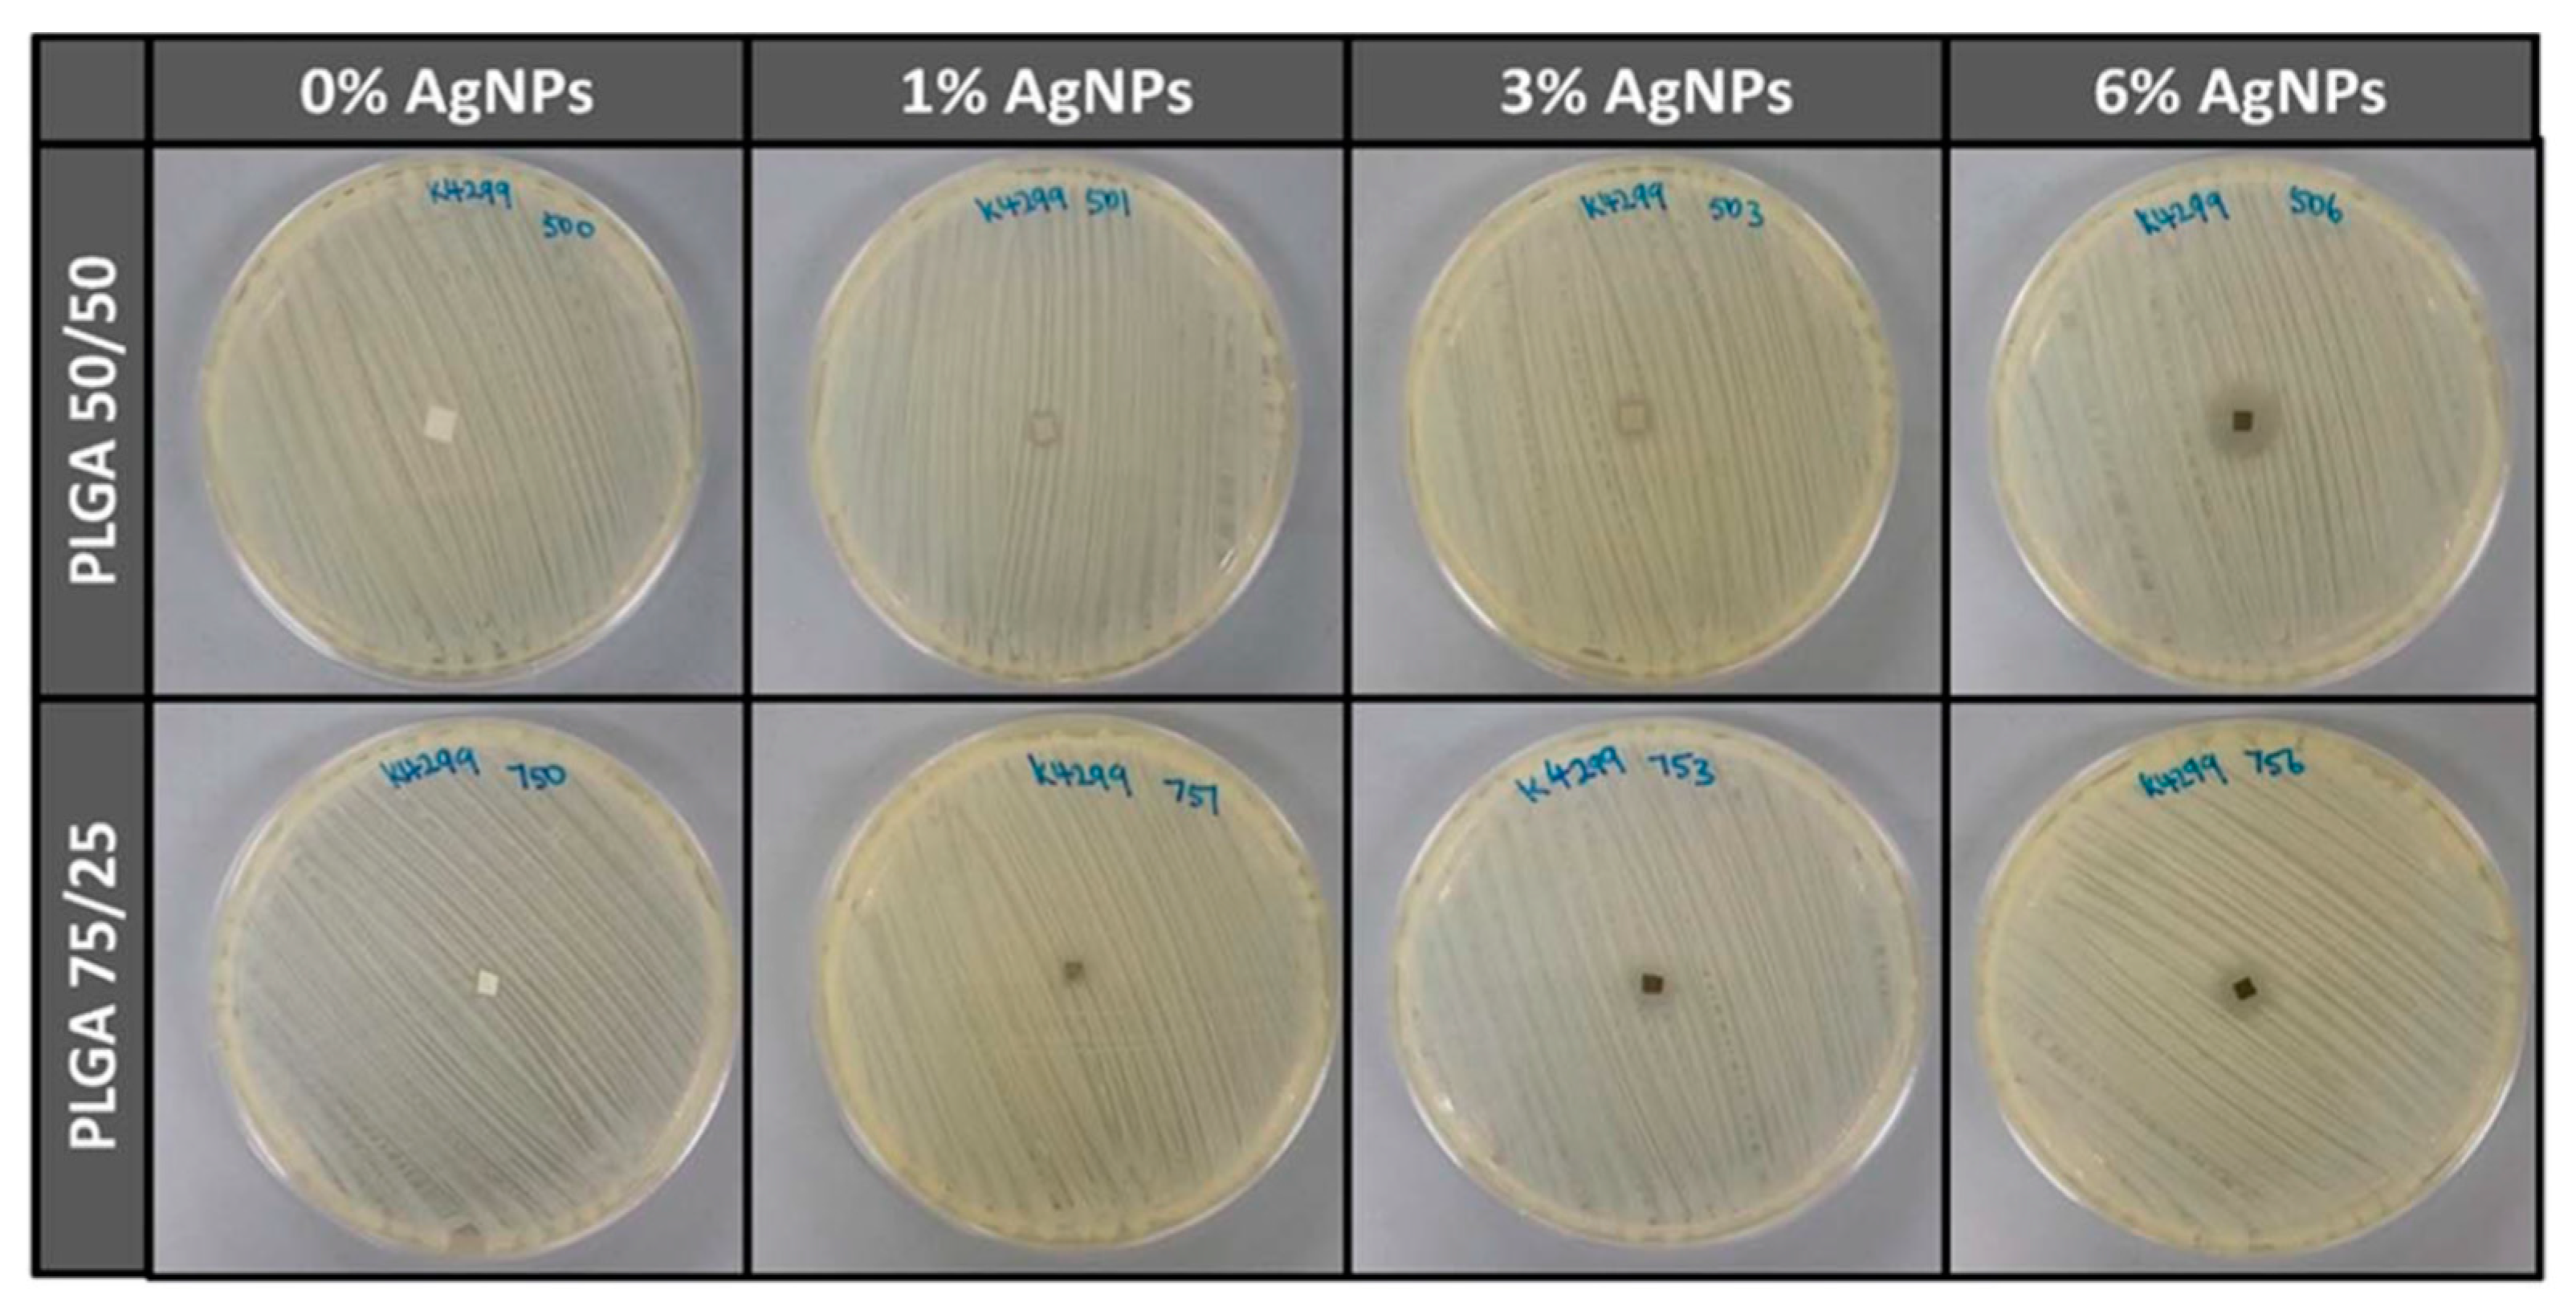

Antibacterial Activities of Aliphatic Polyester Nanocomposites with Silver Nanoparticles and/or Graphene Oxide Sheets
Abstract
1. Introduction
2. Bactericidal Effects of Nanomaterials
2.1. Silver Nanoparticles
Antibacterial Activity
2.2. Graphene Oxide
2.3. GO-AgNPs Nanocomposites
3. Aliphatic Polyester Nanocomposites
3.1. PLA-Based Nanocomposites
3.1.1. PLA/AgNPs Nanocomposites
3.1.2. PLA/GO Nanocomposites
3.1.3. PLA/GO-AgNPs Nanocomposites
3.2. PLGA-Based Nanocomposites
Porous PLGA/AgNPs Scaffolds
3.3. PCL-Based Nanocomposites
3.3.1. PCL/AgNPs Fibrous Mats
3.2.2. PCL/RGO-AgNPs Nanocomposites
4. Mechanical Properties
5. Future Challenges
6. Conclusions
Author Contributions
Funding
Conflicts of Interest
References
- Polívková, M.; Hubáček, T.; Staszek, M.; Švorčík, V.; Siegel, J. Antimicrobial treatment of polymeric medical devices by silver nanomaterials and related technology. Int. J. Mol. Sci. 2017, 18, 419. [Google Scholar] [CrossRef]
- Sánchez-Salcedo, S.; Colilla, M.; Izquierdo-Barba, I.; Vallet-Regi, M. Preventing bacterial adhesion on scaffolds for bone tissue engineering. Int. J. Bioprint. 2016, 2, 20–34. [Google Scholar] [CrossRef]
- Hughes, H.; Webber, M.A. Novel approaches to the treatment of bacterial biofilm infections. Br. J. Pharmacol. 2017, 174, 2237–2246. [Google Scholar] [CrossRef] [PubMed]
- Cunliffe, D.; Smart, A.C.; Alexander, C.; Vulfson, E.N. Bacterial adhesion of synthetic surfaces. Appl. Environ. Microbiol. 1999, 65, 4995–5002. [Google Scholar] [PubMed]
- Renner, L.D.; Weibel, D.B. Physicochemical regulation of biofilm formation. MRS Bull. 2011, 36, 347–355. [Google Scholar] [CrossRef] [PubMed]
- Reffuveille, F.; Josse, J.; Vallé, Q.; Mogaret, C.; Gangloff, S.C. Staphylococcus Aureus Biofilms and their Impact on the Medical Field. In The Rise of Virulence and Antibiotic Resistance in Staphylococcus Aureus; Enany, S., Crotty Alexander, L.E., Eds.; IntechOpen: London, UK, 2017; Chapter 11; ISBN 978-953-51-2984-4. [Google Scholar]
- Li, Y.H.; Tian, X. Quorum sensing and bacterial social interactions in biofilms. Sensors 2012, 12, 2519–2538. [Google Scholar] [CrossRef] [PubMed]
- Flemming, H.C. EPS—Then and now. Microorganisms 2016, 4, 41. [Google Scholar] [CrossRef] [PubMed]
- Orman, M.A.; Mok, W.W.; Brynildsen, M.P. Aminoglycoside-enabled elucidation of bacterial persister metabolism. Curr. Protoc. Microbiol. 2015, 36, 17.9.1–17.9.14. [Google Scholar] [CrossRef]
- Lei, M.G.; Gupta, R.K.; Lee, C.Y. Proteomics of Staphylococcus aureus biofilm matrix in a rat model of orthopedic implant-associated infection. PLoS ONE 2017, 12, e0187981. [Google Scholar] [CrossRef]
- Jacqueline, C.; Caillon, J. Impact of bacterial biofilm on the treatment of prosthetic joint infections. J. Antimicrob. Chemother. 2014, 69, i37–i40. [Google Scholar] [CrossRef]
- Peleg, A.Y.; Hooper, D.C. Hospital-acquired infections due to gram-negative bacteria. N. Engl. J. Med. 2010, 362, 1804–1813. [Google Scholar] [CrossRef]
- Meng, Y.Z.; Tjong, S.C. Rheology and morphology of compatibilized polyamide 6 blends containing liquid crystalline copolyesters. Polymer 1998, 39, 99–107. [Google Scholar] [CrossRef]
- Meng, Y.Z.; Tjong, S.C.; Hay, A.S.; Wang, S.J. Synthesis and proton conductivities of phosphonic acid containing poly-(arylene ether)s. J. Polym. Sci. A Polym. Chem. 2001, 39, 3218–3226. [Google Scholar] [CrossRef]
- Liu, C.; Chan, K.W.; Shen, J.; Liao, C.Z.; Yeung, K.W.K.; Tjong, S.C. Polyetheretherketone hybrid composites with bioactive nanohydroxyapatite and multiwalled carbon nanotube fillers. Polymers 2016, 8, 425. [Google Scholar] [CrossRef]
- Chan, K.W.; Liao, C.Z.; Wong, H.M.; Yeung, K.W.K.; Tjong, S.C. Preparation of polyetheretherketone composites with nanohydroxyapatite rods and carbon nanofibers having high strength, good biocompatibility and excellent thermal stability. RSC Adv. 2016, 6, 19417–19429. [Google Scholar] [CrossRef]
- Liao, C.Z.; Li, K.; Wong, H.M.; Tong, W.Y.; Yeung, K.W.K.; Tjong, S.C. Novel polypropylene biocomposites reinforced with carbon nanotubes and hydroxyapatite nanorods for bone replacements. Mater. Sci. Eng. C 2013, 13, 1380–1388. [Google Scholar] [CrossRef]
- Liao, C.Z.; Wong, H.M.; Yeung, K.W.K.; Tjong, S.C. The development, fabrication and material characterization of polypropylene composites reinforced with carbon nanofiber and hydroxyapatite nanorod hybrid fillers. Int. J. Nanomed. 2014, 9, 1299–1310. [Google Scholar] [CrossRef]
- Liu, C.; Wong, H.M.; Yeung, K.W.; Tjong, S.C. Novel electrospun polylactic acid nanocomposite fiber mats with hybrid graphene oxide and nanohydroxyapatite reinforcements having enhanced biocompatibility. Polymers 2016, 8, 287. [Google Scholar] [CrossRef]
- Prasadh, S.; Wong, R.C. Unraveling the mechanical strength of biomaterials used as a bone scaffold in oral and maxillofacial defects. Oral Sci. Int. 2018, 15, 48–55. [Google Scholar] [CrossRef]
- Sun, X.; Xu, C.; Wu, G.; Ye, Q.; Wang, C. Poly (lactic-co-glycolic acid): Applications and future prospects for periodontal tissue regeneration. Polymers 2017, 9, 189. [Google Scholar] [CrossRef]
- Gao, C.; Peng, S.; Feng, P.; Shuai, C. Bone biomaterials and interactions with stem cells. Bone Res. 2017, 5, 17059. [Google Scholar] [CrossRef]
- Manavitehrani, I.; Fathi, A.; Badr, H.; Daly, S.; Shirazi, A.N.; Dehghani, F. Biomedical applications of biodegradable polyesters. Polymers 2016, 8, 20. [Google Scholar] [CrossRef]
- Nayaranan, G.; Vernekar, V.N.; Kuyinu, E.L.; Laurencin, C.T. Poly (Lactic Acid)-based biomaterials for orthopaedic regenerative engineering. Adv. Drug Deliv. Rev. 2016, 107, 247–276. [Google Scholar] [CrossRef]
- Gentile, P.; Giono, V.; Carmagnola, I.; Hatton, P.V. An overview of poly(lactic-co-glycolic) acid (PLGA)-based biomaterials for bone tissue engineering. Int. J. Mol. Sci. 2014, 15, 3640–3659. [Google Scholar] [CrossRef]
- Okamoto, M.; John, B. Synthetic biopolymer nanocomposites for tissue engineering scaffolds. Prog. Polym. Sci. 2013, 38, 1487–1503. [Google Scholar] [CrossRef]
- Brannigan, R.P.; Dove, A.P. Synthesis, properties and biomedical applications of hydrolytically degradable materials based on aliphatic polyesters and polycarbonates. Biomater. Sci. 2017, 5, 9–21. [Google Scholar] [CrossRef]
- Sánchez-González, S.; Diban, N.; Urtiaga, A. Hydrolytic degradation and mechanical stability of poly(ε-caprolactone)/reduced graphene oxide membranes as scaffolds for in vitro neural tissue regeneration. Membranes 2018, 8, 12. [Google Scholar] [CrossRef]
- Bose, S.; Roy, M.; Bandyopadhyay, A. Recent advances in bone tissue engineering scaffolds. Trends Biotechnol. 2012, 30, 546–554. [Google Scholar] [CrossRef]
- Roseti, L.; Parisi, V.; Petretta, M.; Cavallo, C.; Desando, G.; Bartolotti, I.; Grigolo, B. Scaffolds for bone tissue engineering: State of the art and new perspectives. Mater. Sci. Eng. C 2017, 78, 1246–1262. [Google Scholar] [CrossRef]
- Chen, M.; Yu, Q.; Sun, H. Novel strategies for the prevention and treatment of biofilm related infections. Int. J. Mol. Sci. 2013, 14, 18488–18501. [Google Scholar] [CrossRef]
- Haque, M.; Sartelli, M.; McKimm, J.; Abu Bakar, M. Health care-associated infections—An overview. Infect. Drug Resist. 2018, 11, 2321–2333. [Google Scholar] [CrossRef]
- Bassetti, M.; Vena, A.; Guery, B. How to manage pseudomonas aeruginosa infections. Drugs Contest 2018, 7, 212527. [Google Scholar] [CrossRef]
- Obritsch, M.D.; Fish, D.N.; MacLaren, R.; Jung, R. Nosocomial infections due to multidrug-resistant pseudomonas aeruginosa: Epidemiology and treatment options. Pharmacotherapy 2005, 25, 1353–1364. [Google Scholar] [CrossRef]
- Miroshnichenko, S.; Timofeeva, V.; Permyakova, E.; Ershov, S.; Kiryukhantsev-Korneev, P.; Dvořaková, E.; Shtansky, D.V.; Zajíčková, L.; Solovieva, A.; Manakhov, A. Plasma-coated polycaprolactone nanofibers with covalently bonded platelet-rich plasma enhance adhesion and growth of human fibroblasts. Nanomaterials 2019, 9, 637. [Google Scholar] [CrossRef]
- Stojanovska, E.; Canbay, E.; Pampal, E.S.; Calisir, M.D.; Agmar, O.; Polat, Y.; Simsek, R.; Serhat Gundogdu, N.A.; Akgul, Y.; Killic, A. A review on non-electro nanofibre spinning techniques. RSC Adv. 2016, 6, 83783–83801. [Google Scholar] [CrossRef]
- Mahalingam, S.; Edirisinghe, M. Forming of polymer nanofibers by a pressurised gyration process. Macromol. Rapid Commun. 2013, 34, 1134–1139. [Google Scholar] [CrossRef]
- Xu, S.; Mahalingam, S.; Rohn, J.L.; Ren, G.; Edirisinghe, M. Physio-chemical and antibacterial characteristics of pressure spun nylon nanofibres embedded with functional silver nanoparticles. Mater. Sci. Eng. C 2015, 56, 195–204. [Google Scholar] [CrossRef]
- Xu, S.; Mahalingam, S.; Basnett, P.; Raimi-Abraham, B.; Roy, I.; Craig, D.; Edirisinghe, M. Making nonwoven fibrous poly(ε-caprolactone) constructs for antimicrobial and tissue engineering applications by pressurized melt gyration. Macromol. Mater. Eng. 2016, 301, 922–934. [Google Scholar] [CrossRef]
- Illangakoon, U.E.; Mahalingam, S.; Wang, K.; Cheong, Y.K.; Canales, E.; Ren, G.G.; Cloutman-Green, E.; Edirisinghe, M.; Ciric, L. Gyrospun antimicrobial nanoparticle loaded fibrous polymeric filters. Mater. Sci. Eng. C 2017, 74, 315–324. [Google Scholar] [CrossRef]
- Hong, S.; Mahalingam, S.; Edirisinghe, M. Simultaneous application of pressure-infusion-gyration to generate polymeric nanofibers. Macromol. Mater. Eng. 2017, 302, 1600564. [Google Scholar] [CrossRef]
- Hong, S.; Harker, A.; Edirisinghe, M. Process modeling for the fiber diameter of polymer, spun by pressure-coupled infusion gyration. ACS Omega 2018, 3, 5470–15479. [Google Scholar] [CrossRef]
- Matharu, R.K.; Charani, Z.; Ciric, L.; Illangakoon, U.E.; Edirisinghe, M. Antimicrobial activity of tellurium-loaded polymeric fiber meshes. J. Appl. Polym. Sci. 2018, 135, 46368. [Google Scholar] [CrossRef]
- Matharu, R.K.; Porwal, H.; Ciric, L.; Edirisinghe, M. The effect of graphene–poly (methyl methacrylate) fibres on microbial growth. Interf. Focus 2018, 8, 20170058. [Google Scholar] [CrossRef]
- Brako, F.; Thorogate, R.; Mahalingam, S.; Raimi-Abraham, B.; Craig, D.Q.; Edirisinghe, M. Mucoadhesion of progesterone-loaded drug delivery nanofiber constructs. Appl. Mater. Interfaces 2018, 10, 13381–13389. [Google Scholar] [CrossRef]
- Mahalingam, S.; Homer-Vanniasinkam, S.; Edirisinghe, M. Novel pressurised gyration device for making core-sheath polymer fibres. Mater. Des. 2019, 178, 107846. [Google Scholar] [CrossRef]
- Tjong, S.C.; Chen, H. Nanocrystalline materials and coatings. Mater. Sci. Eng. R Rep. 2004, 45, 1–88. [Google Scholar] [CrossRef]
- Tjong, S.C. Polymer nanocomposite bipolar plates reinforced with carbon nanotubes and graphite nanosheets. Energy Environ. Sci. 2011, 44, 605–626. [Google Scholar] [CrossRef]
- He, L.X.; Tjong, S.C. Facile synthesis of silver-decorated reduced graphene oxide as a hybrid filler material for electrically conductive polymer composites. RSC Adv. 2015, 5, 15070–15076. [Google Scholar] [CrossRef]
- He, L.X.; Tjong, S.C. Nanostructured transparent conductive films: Fabrication, characterization and applications. Mater. Sci. Eng. R Rep. 2016, 109, 1–101. [Google Scholar] [CrossRef]
- He, L.X.; Tjong, S.C. Aqueous graphene oxide-dispersed carbon nanotubes as inks for the scalable production of all-carbon transparent conductive films. J. Mater. Chem. C 2016, 4, 7043–7051. [Google Scholar] [CrossRef]
- Tjong, S.C. Nanocrystalline Materials: Their Synthesis-Structure-Property Relationships and Applications, 2nd ed.; Elsevier: London, UK, 2013; ISBN 9780124077966. [Google Scholar]
- Tjong, S.C.; Liang, G.D. Electrical properties of low-density polyethylene/ZnO nanocomposites. Mater. Chem. Phys. 2006, 100, 1–5. [Google Scholar] [CrossRef]
- Singh, D.P.; Herrera, C.E.; Singh, B.; Singh, S.; Singh, R.K.; Kumar, R. Graphene oxide: An efficient material and recent approach for biotechnological and biomedical applications. Mater. Sci. Eng. C 2017, 86, 173–197. [Google Scholar] [CrossRef]
- Tadyszak, K.; Wychowaniec, J.K.; Litowczenko, J. Biomedical applications of graphene-based structures. Nanomaterials 2018, 8, 944. [Google Scholar] [CrossRef]
- Banerjee, A.A. Graphene and its derivatives as biomedical materials: Future prospects and challenges. Interface Focus 2018, 8, 20170056. [Google Scholar] [CrossRef]
- Zou, X.; Zhang, L.; Wang, Z.; Luo, Y. Mechanisms of the antimicrobial activities of graphene materials. J. Am. Chem. Soc. 2016, 138, 2064–2077. [Google Scholar] [CrossRef]
- Kumar, P.; Huo, P.; Zhang, R.; Liu, B. Antibacterial properties of graphene-based nanomaterials. Nanomaterials 2019, 9, 737. [Google Scholar] [CrossRef]
- Burdușel, A.C.; Gherasim, O.; Grumezescu, A.M.; Mogoantă, L.; Ficai, A.; Andronescu, E. Biomedical applications of silver nanoparticles: An up-to-date overview. Nanomaterials 2018, 8, 681. [Google Scholar] [CrossRef]
- Victor, S.U.; Roberto, V.B. Silver Nanoparticles and PDMS Hybrid Nanostructure for Medical Applications. In Silver Nanoparticles–Fabrication, Characterization and Applications; Maaz, K., Ed.; IntechOpen: London, UK, 2018; Chapter 8. [Google Scholar]
- Palmieri, V.; Bugli, F.; Lauriola, M.C.; Cacaci, M.; Torelli, R.; Ciasca, G.; Conti, C.; Sanguinetti, M.; Papi, M.; De Spirito, M. Bacteria meet graphene: Modulation of graphene oxide nanosheet interaction with human pathogens for effective antimicrobial therapy. ACS Biomater. Sci. Eng. 2017, 3, 619–627. [Google Scholar] [CrossRef]
- Jiang, L.; Zhu, Z.; Wen, Y.; Ye, S.; Su, C.; Zhang, R.; Shao, W. Facile construction of functionalized GO nanocomposites with enhanced antibacterial activity. Nanomaterials 2019, 9, 913. [Google Scholar] [CrossRef]
- Kedziora, A.; Speruda, M.; Krzyzewska, E.; Rybka, Z.; Łukowiak, A.; Bugla-Ploskonska, G. Similarities and differences between silver ions and silver in nanoforms as antibacterial agents. Int. J. Mol. Sci. 2018, 19, 444. [Google Scholar] [CrossRef]
- Qing, Y.; Cheng, L.; Li, R.; Liu, G.; Zhang, Y.; Tang, X.; Wang, J.; Liu, H.; Qin, Y. Potential antibacterial mechanism of silver nanoparticles and the optimization of orthopedic implants by advanced modification technologies. Int. J. Nanomed. 2018, 13, 3311–3327. [Google Scholar] [CrossRef]
- Lee, H.J.; Yeo, S.Y.; Jeong, S.H. Antibacterial effect of nanosized silver colloidal solution on textile fabrics. Mater. Sci. 2003, 38, 2199–2204. [Google Scholar] [CrossRef]
- Perelshtein, I.; Applerot, G.; Perkas, N.; Guibert, G.; Mikhailov, S.; Gedanken, A. Sonochemical coating of silver nanoparticles on textile fabrics (nylon, polyester and cotton) and their antibacterial activity. Nanotechnology 2008, 19, 245705. [Google Scholar] [CrossRef]
- Radetić, M.; Ilić, V.; Vodnik, V.; Dimitrijević, S.; Jovančić, P.; Šaponjić, Z.; Nedeljković, J.M. Antibacterial effect of silver nanoparticles deposited on corona-treated polyester and polyamide fabrics. Polym. Adv. Technol. 2008, 19, 1816–1821. [Google Scholar] [CrossRef]
- Matharu, R.K.; Ciric, L.; Edirisinghe, M. Nanocomposites: Suitable alternatives as antimicrobial agents. Nanotechnology 2018, 29, 282001. [Google Scholar] [CrossRef]
- Tang, J.; Chen, Q.; Xu, L.; Zhang, S.; Feng, L.; Cheng, L.; Xu, H.; Liu, Z.; Peng, R. Graphene oxide–silver nanocomposite as a highly effective antibacterial agent with species-specific mechanisms. ACS Appl. Mater. Interfaces 2013, 5, 3867–3874. [Google Scholar] [CrossRef]
- Shao, W.; Liu, X.; Min, H.; Dong, G.; Feng, Q.; Zuo, X. Preparation, characterization, and antibacterial activity of silver nanoparticle-decorated graphene oxide nanocomposite. ACS Appl. Mater. Interfaces 2015, 7, 6966–6973. [Google Scholar] [CrossRef]
- Das, M.R.; Sarma, R.K.; Saikia, R.; Kale, V.S.; Shelke, M.V.; Sengupta, P. Synthesis of silver nanoparticles in an aqueous suspension of graphene oxide sheets and its antimicrobial activity. Colloids Surf. B 2011, 83, 16–22. [Google Scholar] [CrossRef]
- De Faria, A.F.; Martinez, D.S.T.; Meira, S.M.; de Moraes, A.C.; Brandelli, A.; Filho, A.G.; Alves, O.L. Anti-adhesion and antibacterial activity of silver nanoparticles supported on graphene oxide sheets. Colloids Surf. B 2014, 113, 115–124. [Google Scholar] [CrossRef]
- Liao, C.; Li, Y.; Tjong, S.C. Bactericidal and cytotoxic properties of silver nanoparticles. Int. J. Mol. Sci. 2019, 20, 449. [Google Scholar] [CrossRef]
- De Matteis, V.; Cascione, M.; Toma, C.C.; Leporatti, S. Silver nanoparticles: Synthetic routes, in vitro toxicity and theranostic applications for cancer disease. Nanomaterials 2018, 8, 319. [Google Scholar] [CrossRef]
- Lee, S.H.; Jun, B.H. Silver Nanoparticles: Synthesis and application for nanomedicine. Int. J. Mol. Sci. 2019, 20, 865. [Google Scholar] [CrossRef]
- Abdul Wahab, J.; Kim, I.S.; Ni, Q.Q. A comparative study on synthesis of AgNPs on cellulose nanofibers by thermal treatment and DMF for antibacterial activities. Mater. Sci. Eng. C 2019, 98, 1179–1195. [Google Scholar] [CrossRef]
- Yu, C.; Tang, J.; Liu, X.; Ren, X.; Zhen, M.; Wang, L. Green biosynthesis of silver nanoparticles using Eriobotrya japonica (Thunb.) leaf extract for reductive catalysis. Materials 2019, 12, 189. [Google Scholar] [CrossRef]
- Kumar, S.V.; Bafana, A.P.; Pawar, P.; Rahman, A.; Dahoumane, S.; Jeffreys, C.S. High conversion synthesis of <10 nm starch-stabilized silver nanoparticles using microwave technology. Sci. Rep. 2018, 8, 5106. [Google Scholar] [CrossRef]
- Siddiqi, K.S.; Husen, A.; Rao, R.A. A review on biosynthesis of silver nanoparticles and their biocidal properties. J. Nanobiotechnol. 2018, 16, 14. [Google Scholar] [CrossRef]
- Yuan, Y.G.; Peng, Q.L.; Gurunathan, S. Effects of silver nanoparticles on multiple drug-resistant strains of staphylococcus aureus and pseudomonas aeruginosa from mastitis-infected goats: An alternative approach for antimicrobial therapy. Int. J. Mol. Sci. 2017, 18, 569. [Google Scholar] [CrossRef]
- Su, H.L.; Chou, C.C.; Hung, D.J.; Lin, S.H. The disruption of bacterial membrane integrity through ROS generation induced by nanohybrids of silver and clay. Biomaterials 2009, 30, 5979–5987. [Google Scholar] [CrossRef]
- Morones, J.R.; Elechiguerral, J.L.; Camacho, A.; Holt, K.; Kouri, J.B.; Ramirez, J.T.; Yacaman, M.J. The bactericidal effect of silver nanoparticles. Nanotechnology 2005, 16, 2346–2353. [Google Scholar] [CrossRef]
- Salem, W.; Leitner, D.R.; Zingl, F.G.; Schratter, G.; Prassl, R.; Goessler, W.; Reidl, J.; Schild, S. Antibacterial activity of silver and zinc nanoparticles against Vibrio cholerae and enterotoxic Escherichia coli. Int. J. Med. Microbiol. 2015, 305, 85–95. [Google Scholar] [CrossRef]
- Abbaszadegan, A.; Ghahramani, Y.; Gholami, A.; Hemmateenejad, B.; Dorostkar, S.; Sharghi, H. The effect of charge at the surface of silver nanoparticles on antimicrobial activity against gram-positive and gram-negative bacteria: A preliminary study. J. Nanomater. 2015, 2015, 720654. [Google Scholar] [CrossRef]
- Forest, V.; Pourchez, J. Preferential binding of positive nanoparticles on cell membranes is due to electrostatic interactions: A too simplistic explanation that does not take into account the nanoparticle protein corona. Mater. Sci. Eng. C 2017, 70, 889–896. [Google Scholar] [CrossRef]
- Hsueh, Y.H.; Lin, K.S.; Ke, W.J.; Hsieh, C.T.; Chiang, C.L.; Tzou, D.Y.; Liu, S.T. The antimicrobial properties of silver nanoparticles in Bacillus subtilis are mediated by released Ag+ ions. PLoS ONE 2015, 10, e0144306. [Google Scholar] [CrossRef]
- Tjong, S.C.; Hoffman, R.W.; Yeager, E.B. Electron and ion spectroscopic iron-chromium alloys. J. Electrochem. Soc. 1982, 129, 1662–1668. [Google Scholar] [CrossRef]
- Tjong, S.C.; Yeager, E. ESCA and SIMS studies of the passive film on iron. J. Electrochem. Soc. 1981, 128, 2251–2254. [Google Scholar] [CrossRef]
- Xiu, Z.M.; Zhang, Q.B.; Puppala, H.L.; Colvin, V.L.; Alvarez, P.J. Negligible particle-specific antibacterial activity of silver nanoparticles. Nano Lett. 2012, 12, 4271–4275. [Google Scholar] [CrossRef]
- Randall, C.P.; Oyama, L.B.; Bostock, J.M.; Chopra, I.; O’Neill, A.J. The silver cation (Ag+): Antistaphylococcal activity, mode of action and resistance studies. J. Antimicrob. Chemother. 2013, 68, 131–138. [Google Scholar] [CrossRef]
- Ben-Knaz, R.; Rami Pedahzur, R.; Avnir, D. Bioactive doped metals: High synergism in the bactericidal activity of chlorhexidine@silver towards wound pathogenic bacteria. RSC Adv. 2013, 3, 8009–8015. [Google Scholar] [CrossRef]
- Fordham, W.R.; Redmond, S.; Westerland, A.; Cortyes, E.G.; Walker, C.; Callagher, C.; Medina, C.J.; Waecther, F.; Lunk, C.; Ostrum, R.F.; et al. Silver as a bactericidal coating for biomedical implants. Surf. Coat. Technol. 2014, 253, 52–57. [Google Scholar] [CrossRef]
- Ostrum, R.; Hettinger, J.; Krchnavek, R.; Caputo, G.A. Use of Silver Containing Layers at Implant Surfaces. Patent US 9649338B2, 16 May 2017. [Google Scholar]
- Agnihotri, S.; Mukherji, S.; Mukherji, S. Size-controlled silver nanoparticles synthesized over the range 5–100 nm using the same protocol and their antibacterial efficacy. RSC Adv. 2014, 4, 3974–3983. [Google Scholar] [CrossRef]
- Pal, S.; Tak, Y.K.; Song, J.M. Does the antibacterial activity of silver nanoparticles depend on the shape of the nanoparticle? A study of the Gram-negative bacterium Escherichia coli. Appl. Environ. Microbiol. 2007, 73, 1712–1720. [Google Scholar] [CrossRef]
- Acharya, D.; Singha, K.M.; Pandey, P.; Mohanta, B.; Rajkumari, J.; Singha, L.P. Shape dependent physical mutilation and lethal effects of silver nanoparticles on bacteria. Sci. Rep. 2018, 8, 201. [Google Scholar] [CrossRef]
- Gurunathan, S.; Choi, Y.Z.; Kim, J.H. Antibacterial efficacy of silver nanoparticles on endometritis caused by Prevotella melaninogenica and Arcanobacterum pyogenes in dairy cattle. Int. J. Mol. Sci. 2018, 19, 1210. [Google Scholar] [CrossRef]
- Liao, S.; Zhang, Y.; Pan, X.; Zhu, F.; Jiang, C.; Liu, Q.; Cheng, Z.; Dai, G.; Wu, G.; Wang, L.; et al. Antibacterial activity and mechanism of silver nanoparticles against multidrug-resistant Pseudomonas aeruginosa. Int. J. Nanomed. 2019, 14, 1469–1487. [Google Scholar] [CrossRef]
- Losasso, C.; Belluco, S.; Cibin, V.; Zavagnin, P.; Micetic, I.; Gallocchio, F.; Zanella, M.; Biancotto, G.; Ricci, A. Antibacterial activity of silver nanoparticles: Sensitivity of different Salmonella serovars. Front. Microbiol. 2014, 5, 227. [Google Scholar] [CrossRef]
- Mai-Prochnow, A.; Clauson, M.; Hong, J.; Murphy, A.B. Gram positive and Gram negative bacteria differ in their sensitivity to cold plasma. Sci. Rep. 2016, 6, 38610. [Google Scholar] [CrossRef]
- Gumbart, J.C.; Beeby, M.; Jensen, G.J.; Roux, B. Escherichia coli peptidoglycan structure and mechanics as predicted by atomic-scale simulations. PLoS Comput. Biol. 2014, 10, e1003475. [Google Scholar] [CrossRef]
- Guerrero-Contreras, J.; Caballero-Briones, F. Graphene oxide powders with different oxidation degree, prepared by synthesis variations of the Hummers method. Mater. Chem. Phys. 2015, 153, 209–220. [Google Scholar] [CrossRef]
- Suk, J.W.; Piner, R.D.; An, J.; Ruoff, R.S. Mechanical properties of monolayer graphene oxide. ACS Nano 2010, 4, 6557–6564. [Google Scholar] [CrossRef]
- Feng, H.; Cheng, R.; Zhao, X.; Duan, X.; Li, J. A low-temperature method to produce highly reduced graphene oxide. Nat. Commun. 2013, 4, 1539. [Google Scholar] [CrossRef]
- Ahmad, A.F.; Aziz, S.A.; Abbas, Z.; Obaiys, S.J.; Matori, K.A.; Zaid, M.H.M.; Raad, H.K.; Aliyu, U.S. Chemically reduced graphene oxide-reinforced poly (lactic acid)/poly (ethylene glycol) nanocomposites: Preparation, characterization, and applications in electromagnetic interference shielding. Polymers 2019, 11, 661. [Google Scholar] [CrossRef]
- Cobo Sánchez, C.; Wåhlander, M.; Karlsson, M.; Marin Quintero, D.C.; Hillborg, H.; Malmström, E.; Nilsson, F. Characterization of reduced and surface-modified graphene oxide in poly (ethylene-co-butyl acrylate) composites for electrical applications. Polymers 2019, 11, 740. [Google Scholar] [CrossRef]
- He, L.; Tjong, S.C. A graphene oxide-polyvinylidene fluoride mixture as a precursor for fabricating thermally reduced graphene oxide-polyvinylidene fluoride composites. RSC Adv. 2013, 3, 22981–22987. [Google Scholar] [CrossRef]
- Pourjavadi, A.; Pourbadiei, B.; Doroudian, M.; Azari, S. Preparation of PVA nanocomposites using salep-reduced graphene oxide with enhanced mechanical and biological properties. RSC Adv. 2015, 5, 92428. [Google Scholar] [CrossRef]
- Ege, D.; Kamali, A.R.; Boccaccini, A.R. Graphene oxide/polymer-based biomaterials. Adv. Eng. Mater. 2017, 19, 1700627. [Google Scholar] [CrossRef]
- Rahman, Q.S.; Chellasamy, V.; Ponpandian, N.; Amirthapandian, S.; Panigrahi, B.K.; Thangadurai, P. A facile green synthesis of reduced graphene oxide by using pollen grains of Peltophorum pterocarpum and its electrochemical behavior. RSC Adv. 2014, 4, 56910–56917. [Google Scholar] [CrossRef]
- Hou, D.; Liu, Q.; Wang, X.; Quan, Y.; Qiao, Z.; Yu, L.; Ding, S. Facile synthesis of graphene via reduction of graphene oxide by artemisinin in ethanol. J. Mater. 2018, 4, 256–265. [Google Scholar] [CrossRef]
- McAllister, M.J.; Li, J.L.; Adamson, D.H.; Schniepp, H.C.; Abdala, A.A.; Liu, J.; Herrera-Alonso, M.; Milius, D.L.; Car, R.; Prud’homme, R.K.; et al. Single sheet functionalized graphene by oxidation and thermal expansion of graphite. Chem. Mater. 2007, 19, 4396–4404. [Google Scholar] [CrossRef]
- Prasadh, S.; Suresh, S.; Wong, R. Osteogenic potential of graphene in bone tissue engineering scaffolds. Materials 2018, 11, 1430. [Google Scholar] [CrossRef]
- Shadjou, N.; Hasenzadeh, M.; Khalilzadeh, N. Graphene based scaffolds on bone tissue engineering. Bioengineered 2018, 9, 38–47. [Google Scholar] [CrossRef]
- Kenry Lee, W.C.; Loh, K.P.; Lim, T.C. When stem cells meet graphene: Opportunities and challenges in regenerative medicine. Biomaterials 2018, 155, 236–250. [Google Scholar] [CrossRef]
- Liao, C.; Li, Y.; Tjong, S.C. Graphene nanomaterials: Synthesis, biocompatibility, and cytotoxicity. Int. J. Mol. Sci. 2018, 19, 3564. [Google Scholar] [CrossRef]
- Luo, Y.; Shen, H.; Fang, Y.; Cao, Y.; Huang, J.; Zhang, M.; Dai, J.; Shi, X.; Zhang, Z. Enhanced proliferation and osteogenic differentiation of mesenchymal stem cells on graphene oxide-incorporated electrospun poly (lactic-co-glycolic acid) nanofibrous mats. ACS Appl. Mater. Interfaces 2015, 7, 6331–6339. [Google Scholar] [CrossRef]
- Liang, C.; Luo, Y.; Yang, G.; Xia, D.; Liu, L.; Zhang, X.; Wang, H. Graphene oxide hybridized nHAC/PLGA scaffolds facilitate the proliferation of MC3T3-E1 cells. Nanoscale Res. Lett. 2018, 13, 15. [Google Scholar] [CrossRef]
- Song, J.; Gao, H.; Zhu, G.; Cao, X.; Shi, X.; Wang, Y. The preparation and characterization of polycaprolactone/graphene oxide biocomposite nanofiber scaffolds and their application for directing cell behaviors. Carbon 2015, 95, 1039–1050. [Google Scholar] [CrossRef]
- Li, Y.; Liao, C.; Tjong, S.C. Synthetic biodegradable aliphatic polyester nanocomposites reinforced with nanohydroxyapatite and/or graphene oxide for bone tissue engineering applications. Nanomaterials 2019, 9, 590. [Google Scholar] [CrossRef]
- Akhavan, O.; Ghaderi, E. Toxicity of graphene and graphene oxide nanowalls against bacteria. ACS Nano 2010, 4, 5731–5736. [Google Scholar] [CrossRef]
- Akhavan, O.; Ghaderi, E.; Esfandiar, A. Wrapping bacteria by graphene nanosheets for isolation from environment, reactivation by sonication and inactivation by near-infrared irradiation. J. Phys. Chem. B 2011, 115, 6279–6288. [Google Scholar] [CrossRef]
- Liu, S.; Hu, M.; Zeng, T.H.; Wu, R.; Jiang, R.; Wei, J.; Wang, L.; Kong, J.; Chen, Y. Lateral dimension-dependent antibacterial activity of graphene oxide sheets. Langmuir 2012, 28, 12364–12372. [Google Scholar] [CrossRef]
- Tu, Y.; Lv, M.; Xiu, P.; Huynh, T.; Zhang, M.; Castelli, M.; Liu, Z.; Huang, Q.; Fan, C.; Fang, H. Destructive extraction of phospholipids from Escherichia coli membranes by graphene nanosheets. Nat. Nanotechnol. 2013, 8, 594. [Google Scholar] [CrossRef]
- Lu, X.; Feng, X.; Werber, J.R.; Chu, C.; Zucker, I.; Kim, J.H.; Osuji, J.O.; Elimelech, M. Enhanced antibacterial activity through the controlled alignment of graphene oxide nanosheets. Proc. Natl. Acad. Sci. USA 2017, 114, E9793–E9801. [Google Scholar] [CrossRef]
- Musico, Y.L.; Santos, C.M.; Dalida, M.L.; Rodriques, D.F. Surface modification of membrane filters using graphene and graphene oxide-based nanomaterials for bacterial inactivation and removal. ACS Sustain. Chem. Eng. 2014, 2, 1559–1565. [Google Scholar] [CrossRef]
- Gurunathan, S.; Han, J.W.; Dayem, A.A.; Eppakayala, V.; Kim, J.H. Oxidative stress-mediated antibacterial activity of graphene oxide and reduced graphene oxide in Pseudomonas aeruginosa. Int. J. Nanomed. 2012, 7, 5901–5914. [Google Scholar] [CrossRef]
- Farid, M.A.; Jeong, S.; Seo, D.H.; Ahmed, R.; Lau, C.; Gali, N.K.; Ning, Z.; An, A.K. Mechanistic insight into the in vitro toxicity of graphene oxide against biofilm forming bacteria using laser-induced breakdown spectroscopy. Nanoscale 2018, 10, 4475–4487. [Google Scholar] [CrossRef]
- Szunerits, S.; Boukherroub, R. Antibacterial activity of graphene-based materials. J. Mater. Chem. B 2016, 4, 6892–6912. [Google Scholar] [CrossRef]
- Gurunathan, S.; Kim, J. Synthesis, toxicity, biocompatibility, and biomedical applications of graphene and graphene-related materials. Int. J. Nanomed. 2016, 11, 1927–1945. [Google Scholar] [CrossRef]
- Gusev, A.; Zakharova, O.; Vasyukova, I.; Muratov, D.S.; Rybkin, I.; Bratashov, D.; Lapanje, A.; Il’inikh, I.; Kolesnikov, E.; Kuznetsov, D. Effect of GO on bacterial cells: Role of the medium type and electrostatic interactions. Mater. Sci. Eng. C 2019, 99, 275–281. [Google Scholar] [CrossRef]
- Zhou, X.; Huang, X.; Qi, X.; Wu, S.; Xue, C.; Boey, F.Y.; Yan, Q.; Chen, P.; Zhang, H. In situ synthesis of metal nanoparticles on single-layer graphene oxide and reduced graphene oxide surfaces. J. Phys. Chem. C 2009, 113, 10842–10846. [Google Scholar] [CrossRef]
- Pasricha, R.; Gupta, S.; Srivastava, A.K. A facile and novel synthesis of Ag–graphene-based nanocomposites. Small 2009, 5, 2253–2259. [Google Scholar] [CrossRef]
- Khorrami, S.; Abdollahi, Z.; Eshaghi, G.; Khosravi, A.; Bidram, E.; Zarrabi, A. An Improved method for fabrication of Ag-GO nanocomposite with controlled anti-cancer and anti-bacterial behavior; A comparative study. Sci. Rep. 2019, 9, 9167. [Google Scholar] [CrossRef]
- De Moraes, A.C.; Lima, B.A.; de Faria, A.F.; Brocchi, M.; Alves, O.L. Graphene oxide-silver nanocomposite as a promising biocidal agent against methicillin-resistant Staphylococcus aureus. Int. J. Nanomed. 2015, 10, 6847–6861. [Google Scholar] [CrossRef]
- Prasad, K.; Lekshmi, G.S.; Ostrikov, K.; Lussini, V.; Blinco, J.; Mohandas, M.; Vasilev, K.; Bottle, S.; Bazaka, K.; Ostrikov, K. Synergic bactericidal effects of reduced graphene oxide and silver nanoparticles against Gram-positive and Gram-negative bacteria. Sci. Rep. 2017, 7, 1591. [Google Scholar] [CrossRef]
- Jaworski, S.; Wierzbicki, M.; Sawosz, S.; Jung, A.; Gielerak, G.; Biernat, J.; Jaremek, H.; Łojkowski, W.; Woźniak, B.; Wojnarowicz, J.; et al. Graphene oxide-based nanocomposites decorated with silver nanoparticles as an antibacterial agent. Nanoscale Res. Lett. 2018, 13, 116. [Google Scholar] [CrossRef]
- Vi, T.T.T.; Kumar, S.R.; Rout, B.; Liu, C.H.; Wong, C.B.; Chang, C.W.; Chen, C.H.; Chen, D.W.; Lue, S.J. The preparation of graphene oxide-silver nanocomposites: The effect of silver loads on gram-positive and gram-negative antibacterial activities. Nanomaterials 2018, 8, 163. [Google Scholar] [CrossRef]
- Cheung, G.Y.; Rigby, K.; Wang, R.; Queck, S.Y.; Braughton, K.R.; Whitney, A.R.; Teintze, M.; DeLeo, F.R.; Otto, M. Staphylococcus epidermidis strategies to avoid killing by human neutrophils. PLoS Pathog. 2010, 6, e1001133. [Google Scholar] [CrossRef]
- Tie, D.; Feyerabend, F.; Muller, W.D.; Schade, R.; Liefeith, K.; Kainer, K.U.; Willumeit, R. Antibacterial biodegradable Mg-Ag alloys. Eur. Cells Mater. 2013, 25, 284–298. [Google Scholar] [CrossRef]
- Brennan, S.A.; Fhoghlú, C.N.; Devitt, B.M.; O’ Mahony, F.J.; Brabazon, D.; Walsh, A. Silver nanoparticles and their orthopaedic applications. Bone Jt. J. 2015, 97, 582–589. [Google Scholar] [CrossRef]
- Gallo, J.; Panacek, A.; Prucek, R.; Kriegova, E.; Hradilova, S.; Hobza, M.; Holinka, M. Silver nanocoating technology in the prevention of prosthetic joint infection. Materials 2016, 9, 337. [Google Scholar] [CrossRef]
- Wang, J.; Li, J.; Guo, G.; Wang, Q.; Tang, J.; Zhao, Y.; Qin, H.; Wahafu, T.; Shen, H.; Liu, X.; et al. Silver-nanoparticles-modified biomaterial surface resistant to staphylococcus: New insight into the antimicrobial action of silver. Sci. Rep. 2016, 6, 32699. [Google Scholar] [CrossRef]
- Zheng, Z.; Yin, Y.; Zara, J.N.; Li, W.; Kwak, J.; Mamidi, R.; Lee, M.; Siu, R.K.; Ngo, R.; Wang, J. The use of BMP-2 coupled–Nanosilver-PLGA composite grafts to induce bone repair in grossly infected segmental defects. Biomaterials 2010, 31, 9293–9300. [Google Scholar] [CrossRef]
- Mao, D.; Li, Q.; Li, D.; Chen, Y. Fabrication of 3D porous poly (lactic acid)-based composite scaffolds with tunable biodegradation for bone tissue engineering. Mater. Des. 2018, 142, 1–10. [Google Scholar] [CrossRef]
- Zaiss, S.; Brown, T.D.; Reichert, J.C.; Berner, A. Poly (ε-caprolactone) scaffolds fabricated by melt electrospinning for bone tissue engineering. Materials 2016, 9, 232. [Google Scholar] [CrossRef]
- Fu, C.; Bai, H.; Zhu, J.; Niu, Z.; Wang, Y.; Li, J.; Yang, X.; Bai, Y. Enhanced cell proliferation and osteogenic differentiation in electrospun PLGA/hydroxyapatite nanofiber scaffolds incorporated with graphene oxide. PLoS ONE 2017, 12, e0188352. [Google Scholar] [CrossRef]
- Abedalwafa, M.; Wang, F.; Wang, L.; Li, C. Biodegradable Poly-epsilon-caprolactone (PCL) for tissue engineering applications: A review. Rev. Adv. Mater. Sci. 2013, 34, 123–140. [Google Scholar]
- Nhi, T.T.; Minh, H.H.; Nam, T.M.; Thien, D.B.; Hoai, N.T.; Phuoc, T.V.; Thai, D.M.; Hai, N.D.; Toi, V.V.; Hiep, N.T. Optimization and characterization of electrospun polycaprolactone coated with gelatin-silver nanoparticles for wound healing application. Mater. Sci. Eng. C 2018, 91, 318–329. [Google Scholar] [CrossRef]
- Jun, I.; Han, H.S.; Edwards, J.R.; Jeon, H. Electrospun fibrous scaffolds for tissue engineering: Viewpoints on architecture and fabrication. Int. J. Mol. Sci. 2018, 19, 745. [Google Scholar] [CrossRef]
- Hamad, K.; Kaseem, M.; Yang, H.M.; Deri, F.; Ko, Y.G. Properties and medical applications of polylactic acid: A review. Express Polym. Lett. 2015, 9, 435–455. [Google Scholar] [CrossRef]
- Shameli, K.; Ahmad, M.B.; Yunus, W.M.; Ibrahim, N.A.; Rahman, R.A.; Jokar, M.; Darroudi, M. Silver/poly (lactic acid) nanocomposites: Preparation, characterization, and antibacterial activity. Int. J. Nanomed. 2010, 5, 573–579. [Google Scholar] [CrossRef]
- Aflori, M.; Butnaru, M.; Tihauan, B.M.; Doroftei, F. Eco-friendly method for tailoring biocompatible and antimicrobial surfaces of poly-L-lactic acid. Nanomaterials 2019, 9, 428. [Google Scholar] [CrossRef]
- Liu, C.; Chan, K.W.; Shen, J.; Wong, H.M.; Yeung, K.W.; Tjong, S.C. Melt-compounded polylactic acid composite hybrids with hydroxyapatite nanorods and silver nanoparticles: Biodegradation, antibacterial ability, bioactivity and cytotoxicity. RSC Adv. 2015, 5, 72288–72299. [Google Scholar] [CrossRef]
- Akter, M.; Sikder, M.T.; Rahman, M.; Ullah, A.K.; Hossain, K.F.; Banik, S.; Hosokawa, T.; Saito, T.; Kurasaki, M. A systematic review on silver nanoparticles-induced cytotoxicity: Physicochemical properties and perspectives. J. Adv. Res. 2018, 9, 1–16. [Google Scholar] [CrossRef]
- Castiglioni, S.; Cazzaniga, A.; Locatelli, L.; Maier, J.A.M. Silver nanoparticles in orthopedic applications: New insights on their effects on osteogenic cells. Nanomaterials 2017, 7, 124. [Google Scholar] [CrossRef]
- Xu, X.; Yang, Q.; Wang, Y.; Yu, H.; Chen, X.; Jing, X. Biodegradable electrospun poly (L-lactide) fibers containing antibacterial silver nanoparticles. Eur. Polym. J. 2006, 42, 2081–2087. [Google Scholar] [CrossRef]
- Chen, C.; Sun, X.; Pan, W.; Hou, Y.; Liu, R.; Jiang, X.; Zhang, L. Graphene oxide-templated synthesis of hydroxyapatite nanowhiskers to improve the mechanical and osteoblastic performance of poly (lactic acid) for bone tissue regeneration. ACS Sustain. Chem. Eng. 2018, 6, 3862–3869. [Google Scholar] [CrossRef]
- Pinto, A.M.; Moreira, S.; Goncalves, I.C.; Gama, F.M.; Mendes, A.M.; Magalhaes, F.D. Biocompatibility of poly (lactic acid) with incorporated graphene-based materials. Colloids Surf. B Biointerfaces 2013, 104, 229–238. [Google Scholar] [CrossRef]
- Arriagada, P.; Palza, H.; Palma, P.; Flores, M.; Caviedes, P. Poly (lactic acid) composites based on graphene oxide particles with antibacterial behavior enhanced by electrical stimulus and biocompatibility. J. Biomed. Mater. Res. A 2018, 106, 1051–1060. [Google Scholar] [CrossRef]
- Huang, Y.; Wang, T.; Zhao, X.; Wang, X.; Zhou, L.; Yang, Y.; Liao, F.; Ju, Y. Poly (lactic acid)/graphene oxide—ZnO nanocomposite films with good mechanical, dynamic mechanical, anti—UV and antibacterial properties. J. Chem. Technol. Biotechnol. 2015, 90, 1677–1684. [Google Scholar] [CrossRef]
- Zhang, Q.; Tu, Q.; Hickey, M.E.; Xiao, J.; Gao, B.; Tian, C.; Heng, P.; Jiao, Y.; Peng, T.; Wang, J. Preparation and study of the antibacterial ability of graphene oxide-catechol hybrid polylactic acid nanofiber mats. Colloids Surf. B Biointerf. 2018, 172, 496–509. [Google Scholar] [CrossRef]
- Trentin, D.S.; Silva, D.B.; Frasson, A.P.; Rzhepishevska, O.; da Silva, M.V.; Pulcini, E.; James, G.; Soares, G.V.; Tasca, T.; Ramstedt, M.; et al. Natural green coating inhibits adhesion of clinically important bacteria. Sci. Rep. 2015, 5, 8187. [Google Scholar] [CrossRef]
- Li, J.; Wang, G.; Zhu, H.; Zhang, M.; Zheng, X.; Di, Z.; Liu, X.; Wang, X. Antibacterial activity of large-area monolayer graphene film manipulated by charge transfer. Sci. Rep. 2014, 4, 4359. [Google Scholar] [CrossRef]
- Liu, C.; Shen, J.; Yeung, K.W.K.; Tjong, S.C. Development and antibacterial performance of novel polylactic acid-graphene oxide-silver nanoparticle hybrid nanocomposite mats prepared by electrospinning. ACS Biomater. Sci. Eng. 2017, 3, 471–486. [Google Scholar] [CrossRef]
- Kennedy, K.M.; Bhaw-Luximon, A.; Jhurry, D. Cell-matrix mechanical interaction in electrospun polymeric scaffolds for tissue engineering: Implications for scaffold design and performance. Acta Mater. 2017, 50, 41–55. [Google Scholar] [CrossRef]
- Liu, C.; Shen, J.; Liao, C.Z.; Yeung, K.W.K.; Tjong, S.C. Novel electrospun polyvinylidene fluoride-graphene oxide-silver nanocomposite membranes with protein and bacterial antifouling characteristics. Express Polym. Lett. 2018, 12, 365–382. [Google Scholar] [CrossRef]
- Roesslein, M.; Hirsch, C.; Kaiser, J.P.; Krug, H.F.; Wick, P. Comparability of in vitro tests for bioactive nanoparticles: A common assay to detect reactive oxygen species as an example. Int. J. Mol. Sci. 2013, 14, 24320–24337. [Google Scholar] [CrossRef]
- Scavone, M.; Armentano, H.; Fortunati, E.; Cristofaro, F.; Mattioli, S.; Torre, L.; Kenny, J.M.; Imbriani, M.; Arciola, C.R.; Visai, L. Antimicrobial properties and cytocompatibility of PLGA/Ag nanocomposites. Materials 2016, 9, 37. [Google Scholar] [CrossRef]
- Rinaldi, S.; Fortunati, E.; Taddei, M.; Kenny, J.M.; Armentano, I.; Latterini, L. Integrated PLGA–Ag nanocomposite systems to control the degradation rate and antibacterial properties. J. Appl. Polym. Sci. 2013, 130, 1185–1193. [Google Scholar] [CrossRef]
- Almajhdi, F.N.; Fouad, H.; Khalil, K.A.; Awad, H.M.; Mohamed, S.H.; Elsarnagawy, T.; Albarrag, A.M.; Al-Jassir, F.F.; Abdo, H.S. In-vitro anticancer and antimicrobial activities of PLGA/silver nanofiber composites prepared by electrospinning. J. Mater. Sci. Mater. Med. 2014, 25, 1045–1053. [Google Scholar] [CrossRef]
- Gora, A.; Prabhakaran, M.P.; Eunice, G.T.; Lakshminarayanan, R.; Ramakrishna, S. Silver nanoparticle incorporated poly (L-lactide-co-glycolide) nanofibers: Evaluation of their biocompatibility and antibacterial properties. J. Appl. Polym. Sci. 2015, 132, 42686. [Google Scholar] [CrossRef]
- De Faria, A.F.; Perreault, F.; Shaulsky, E.; Chavez, A.H.; Elimelech, M. Antimicrobial electrospun biopolymer nanofiber mats functionalized with graphene oxide–silver nanocomposites. ACS Appl. Mater. Interfaces 2015, 7, 12751–12759. [Google Scholar] [CrossRef]
- Guarino, G.; Gentile, G.; Sorrentino, L.; Ambrosio, L. Polycaprolactone: Synthesis, Properties, and Applications. In Encyclopedia of Polymer Science and Technology, 4th ed.; Mark, H.F., Ed.; Wiley: Hoboken, NJ, USA, 2014; ISBN 978-1-118-63389-2. [Google Scholar]
- Almeida, B.C.; Figueiredo, P.; Carvalho, A.T. Polycaprolactone enzymatic hydrolysis: A mechanistic study. ACS Omega 2019, 4, 6769–6774. [Google Scholar] [CrossRef]
- Wang, W.; Caetano, G.; Ambler, W.A.; Blaker, J.J.; Frade, M.A.; Mandal, P.; Diver, C.; Bártolo, P.J. Enhancing the hydrophilicity and cell attachment of 3D printed PCL/graphene scaffolds for bone tissue engineering. Materials 2016, 9, 992. [Google Scholar] [CrossRef]
- Duan, J.; Xie, Y.; Yang, J.; Huang, T.; Zhang, N.; Wang, Y.; Zhang, J. Graphene oxide induced hydrolytic degradation behavior changes of poly(l-lactide) in different mediums. Polym. Test. 2016, 56, 220–228. [Google Scholar] [CrossRef]
- Augustine, R.; Kalarikka, K.; Thomas, S. Electrospun PCL membranes incorporated with biosynthesized silver nanoparticles as antibacterial wound dressings. Appl. Nanosci. 2016, 6, 337–344. [Google Scholar] [CrossRef]
- Dobrzanski, L.A.; Hudecki, A.; Chladek, G.; Krol, W.; Mertas, A. Surface properties and antimicrobial activity of composite nanofibers of polycaprolactone with silver precipitations. Arch. Mater. Sci. Eng. 2014, 74, 53–60. [Google Scholar]
- Binkley, D.M.; Lee, B.E.; Saem, S.; Moran-Mirabal, J.; Grandfield, K. Fabrication of polycaprolactone electrospun nanofibers doped with silver nanoparticles formed by air plasma treatment. Nanotechnology 2019, 30, 215101. [Google Scholar] [CrossRef]
- Du, L.; Xu, H.Z.; Li, T.; Zhang, Y.; Zou, F.Y. Fabrication of ascorbyl palmitate loaded poly (caprolactone)/silver nanoparticle embedded poly (vinyl alcohol) hybrid nanofibre mats as active wound dressings via dual-spinneret electrospinning. RSC Adv. 2017, 7, 31310–31318. [Google Scholar] [CrossRef]
- Nhi, T.T.; Khon, H.C.; Hoai, N.T.; Bao, B.C.; Quyen, T.N.; Toi, V.V.; Hiep, N.T. Fabrication of electrospun polycaprolactone coated with chitosan-silver nanoparticles membranes for wound dressing applications. J. Mater. Sci. Mater. Med. 2016, 27, 156. [Google Scholar] [CrossRef]
- Liu, M.; Luo, G.; Wang, Y.; He, W.; Liu, T.; Zhou, D.; Hu, X.; Xing, M.; Wu, J. Optimization and integration of nanosilver on polycaprolactone nanofibrous mesh for bacterial inhibition and wound healing in vitro and in vivo. Int. J. Nanomed. 2017, 12, 6827–6840. [Google Scholar] [CrossRef]
- Liu, L.; Cai, R.; Wang, Y.; Tao, G.; Ai, L.; Wang, P.; Yang, M.; Zuo, H.; Zhao, P.; He, H. Polydopamine-assisted silver nanoparticle self-assembly on sericin/agar film for potential wound dressing application. Int. J. Mol. Sci. 2018, 19, 2875. [Google Scholar] [CrossRef]
- Garcia-Patino, M.D.; García-Contreras, R.; Licona-Limon, P. The immune response against Acinetobacter baumannii, an emerging pathogen in nosocomial infections. Front. Immunol. 2017, 8, 441. [Google Scholar] [CrossRef]
- Dinh, D.; Hui, K.; Hui, K.; Cho, Y.; Zhou, W.; Hong, X.; Chun, H.H. Green synthesis of high conductivity silver nanoparticle-reduced graphene oxide composite films. Appl. Surf. Sci. 2014, 298, 62–67. [Google Scholar] [CrossRef]
- Kumar, S.; Raj, S.; Jain, S.; Chatterjee, K. Multifunctional biodegradable polymer nanocomposite incorporating graphene-silver hybrid for biomedical applications. Mater. Des. 2016, 108, 319–332. [Google Scholar] [CrossRef]
- Chen, Q.; Shou, P.; Zheng, C.; Jiang, M.; Cao, G.; Yang, Q.; Cao, J.; Xie, N.; Velletri, T.; Zhang, X.; et al. Fate decision of mesenchymal stem cells: Adipocytes or osteoblasts? Cell Death Differ. 2016, 23, 1128–1139. [Google Scholar] [CrossRef]
- Pauksch, L.; Hartmann, S.; Rohnke, M.; Szalay, G.; Alt, V.; Schnettler, R.; Lips, K.S. Biocompatibility of silver nanoparticles and silver ions in primary human mesenchymal stem cells and osteoblasts. Acta Biomater. 2014, 10, 439–449. [Google Scholar] [CrossRef]
- Greulich, C.; Braun, D.; Peetsch, A.; Diendorf, J.; Siebers, B.; Epple, M.; Koller, M. The toxic effect of silver ions and silver nanoparticles towards bacteria and human cells occurs in the same concentration range. RSC Adv. 2012, 2, 6981–6987. [Google Scholar] [CrossRef]
- Li, W.; Xu, Z.; Chen, L.; Shan, M.; Tian, X.; Yang, C.; Lv, H.; Qian, X. A facile method to produce graphene oxide-g-poly (L-lactic acid) as an promising reinforcement for PLLA nanocomposites. Chem. Eng. J. 2014, 237, 291–299. [Google Scholar] [CrossRef]
- Wan, C.; Chen, B. Poly (ε-caprolactone)/graphene oxide biocomposites: Mechanical properties and bioactivity. Biomed. Mater. 2011, 6, 055010. [Google Scholar] [CrossRef]
- Chu, Z.; Zhao, T.; Li, L.; Fan, J.; Qin, Y. Characterization of antimicrobial poly (lactic acid)/nano-composite films with silver and zinc oxide nanoparticles. Materials 2017, 10, 659. [Google Scholar] [CrossRef]
- Wang, G.S.; Wei, Z.Y.; Sang, L.; Chen, G.Y.; Zhang, W.X.; Dong, X.F.; Qi, M. Morphology, crystallization and mechanical properties of poly(ε-caprolactone)/graphene oxide nanocomposites. Chin. J. Polym. Sci. 2013, 31, 1148–1160. [Google Scholar] [CrossRef]
- Ramazani, S.; Karimi, M. Aligned poly (ε-caprolactone)/graphene oxide and reduced graphene oxide nanocomposite nanofibers: Morphological, mechanical and structural properties. Mater. Sci. Eng. C 2015, 56, 325–334. [Google Scholar] [CrossRef]
- Bost, M.; Houdart, S.; Oberli, M.; Kalonji, E.; Huneau, J.F.; Margarities, I. Dietary copper and human health: Current evidence and unresolved issues. J. Trace Elem. Med. Biol. 2016, 35, 107–115. [Google Scholar] [CrossRef]
- Champagne, V.K.; Helfritch, D.J. A demonstration of the antimicrobial effectiveness of various copper surfaces. J. Biol. Eng. 2013, 7, 8. [Google Scholar] [CrossRef]
- Schmidt, M.G.; Attaway, H.H.; Sharpe, P.A.; John, J.; Sepkowitz, K.A.; Morgan, A.; Fairey, S.E.; Singh, S.; Steed, L.L.; Cantey, J.R.; et al. Sustained reduction of microbial burden on common hospital surfaces through the introduction of copper. J. Clin. Microbiol. 2012, 50, 2217–2223. [Google Scholar] [CrossRef]
- Michels, H.T.; Keevil, C.W.; Salgado, C.D.; Schmidt, M.G. From laboratory research to a clinical trial: Copper alloy surfaces kill bacteria and reduce hospital-acquired infections. Herd 2015, 9, 64–79. [Google Scholar] [CrossRef]
- Santo, C.E.; Lam, E.W.; Elowsky, C.G.; Quaranta, D.; Domaille, D.W.; Chang, C.J.; Grass, G. Bacterial killing by dry metallic copper surfaces. Appl. Environ. Microbiol. 2011, 77, 794–802. [Google Scholar] [CrossRef]
- Chatterjee, A.K.; Sarkar, R.K.; Chattopadhyay, A.P.; Aich, P.; Chakraborty, R.; Basu, T. A simple robust method for synthesis of metallic copper nanoparticles of high antibacterial potency against E. Coli. Nanotechnology 2012, 23, 085103. [Google Scholar] [CrossRef]
- Usman, M.S.; Zowalaty, M.E.; Shameli, K.; Zainuddin, N.; Salama, M.; Ibrahim, N.A. Synthesis, characterization, and antimicrobial properties of copper nanoparticles. Int. J. Nanomed. 2013, 8, 4467–4479. [Google Scholar] [CrossRef]
- Rosenberg, M.; Vija, H.; Kahru, A.; Keevil, W.; Ivask, A. Rapid in situ assessment of Cu-ion mediated effects and antibacterial efficacy of copper surfaces. Sci. Rep. 2018, 8, 8172. [Google Scholar] [CrossRef]
- Yoon, K.Y.; Hoon, B.J.; Park, J.H.; Hwang, J. Susceptibility constants of Escherichia coli and Bacillus subtilis to silver and copper nanoparticles. Sci. Total Environ. 2007, 373, 572–575. [Google Scholar] [CrossRef]
- Cioffi, N.; Torsi, L.; Ditarantano, N.; Tantalillo, G.; Ghibelli, L.; Sabbatini, L.; Bleve-Zacheo, T.; D’Alessio, M.; Zambonin, P.G.; Traversa, E. Copper nanoparticle/ polymer composites with antifungal and bacteriostatic properties. Chem. Mater. 2005, 17, 5255–5262. [Google Scholar] [CrossRef]
- Cai, S.; Xia, X.; Xie, C. Corrosion behavior of copper/LDPE nanocomposites in simulated uterine solution. Biomaterials 2005, 26, 2671–2676. [Google Scholar] [CrossRef]
- Usman, M.S.; Ibrahim, N.A.; Shameli, K.; Zainuddin, N.; Yunus, W.N. Copper nanoparticles mediated by chitosan: Synthesis and characterization via chemical methods. Molecules 2012, 17, 14928–14936. [Google Scholar] [CrossRef]
- Dang, T.M.; Le, T.T.; Fribourg-Blanc, E.; Dang, M.C. The influence of solvents and surfactants on the preparation of copper nanoparticles by a chemical reduction method. Adv. Nat. Sci. Nanosci. Nanotechnol. 2011, 2, 02500. [Google Scholar] [CrossRef]
- Murugan, K.; Choonara, Y.E.; Kumar, P.; Du Toit, L.C.; Pillay, V. Neo-geometric copper nanocrystals by competitive, dual surfactant-mediated facet adsorption controlling skin permeation. Materials 2016, 9, 966. [Google Scholar] [CrossRef]
- Brusauskaite, L.; Bironaite, D.; Bagdonas, E.; Bernotiene, E. Scaffolds and cells for tissue regeneration: Different scaffold pore sizes—Different cell effects. Cytotechnology 2016, 68, 355–369. [Google Scholar] [CrossRef]
- Liu, H.; He, H.; Peng, X.; Huang, B.; Li, J. Three-dimensional printing of poly (lactic acid) bio-based composites with sugarcane bagasse fiber: Effect of printing orientation on tensile performance. Polym. Adv. Technol. 2019, 30, 910–922. [Google Scholar] [CrossRef]
- Jaidev, L.R.; Chatterjee, K. Surface functionalization of 3D printed polymer scaffolds to augment stem cell response. Mater. Des. 2019, 161, 44–54. [Google Scholar] [CrossRef]

| Specimen | Processing Techniques | Modulus of Elasticity, MPa | Tensile Strength, MPa | Elongation, % | Ref. |
|---|---|---|---|---|---|
| PLA | Solvent casting | 3118.8 | 47.8 | 5.35 | [193] |
| PLA | Solvent casting & compression | NA | 35 | 6.50 | [191] |
| PLA/0.5 wt% GO | Solvent casting & compression | NA | 53 | 8.91 | [191] |
| PCL | Solvent casting & compression | 209 ± 21 | 14.2 ± 1.6 | 554 ± 72 | [192] |
| PCL/1 wt% GO | Solvent casting & compression | 305 ± 35 | 21.8 ± 5.6 | 597 ± 45 | [192] |
| PCL/2 wt% GO | Solvent casting & compression | 442 ± 35 | 27.5 ± 5.7 | 548 ± 81 | [192] |
| PCL | Polymerization & hot pressing | 414 ± 24 | 13.9 ± 1.2 | 478 ± 42 | [194] |
| PCL/1 wt% GO | Polymerization & hot pressing | 578 ± 21 | 26.5 ± 2.4 | 402 ± 4 | [194] |
| PLA/0.5 wt% AgNPs | Solvent casting | 2811.8 | 44.3 | 6.68 | [193] |
| Specimen | Modulus of Elasticity, MPa | Tensile Strength, MPa | Elongation, % | Reference |
|---|---|---|---|---|
| (I) PLA-based system | ||||
| PLA | 8.70 ± 0.90 | 0.76 ± 0.04 | NA | [165] |
| PLA/1 wt% AgNPs | 269.59 ± 6.51 | 1.67 ± 0.12 | NA | [165] |
| PLA/3 wt% AgNPs | 412.23 ± 8.54 | 3.06 ± 0.54 | NA | [165] |
| PLA/7 wt% AgNPs | 968.05 ± 12.71 | 4.65 ± 0.76 | NA | [165] |
| PLA/1 wt% GO | 147.78 ± 3.46 | 1.22 ± 0.12 | NA | [165] |
| PLA/1 wt% GO-1 wt%AgNPs | 377.09 ± 5.33 | 2.06 ± 0.20 | NA | [165] |
| PLA/1 wt% GO-3 wt%AgNPs | 755.40 ± 8.80 | 3.71 ± 0.48 | NA | [165] |
| PLA/1 wt% GO-7 wt%AgNPs | 1211.05 ± 13.53 | 5.46 ± 0.81 | NA | [165] |
| (II) PCL-based system | ||||
| PCL | 2.84 ± 0.87 | 1.24 ± 0.21 | 250 ± 8 | [178] |
| PCL/0.5 wt% AgNPs | 4.28 ± 1.28 | 2.78 ± 0.18 | 427 ± 16 | [178] |
| PCL/1 wt% AgNPs | 2.97 ± 0.59 | 1.23 ± 0.08 | 251 ± 11 | [178] |
| PCL | 10.5 ± 0.92 | 2.37 ± 0.09 | NA | [192] |
| PCL/0.3 wt% GO | 17.4 ± 1.25 | 4.61 ± 0.15 | NA | [192] |
© 2019 by the authors. Licensee MDPI, Basel, Switzerland. This article is an open access article distributed under the terms and conditions of the Creative Commons Attribution (CC BY) license (http://creativecommons.org/licenses/by/4.0/).
Share and Cite
Liao, C.; Li, Y.; Tjong, S.C. Antibacterial Activities of Aliphatic Polyester Nanocomposites with Silver Nanoparticles and/or Graphene Oxide Sheets. Nanomaterials 2019, 9, 1102. https://doi.org/10.3390/nano9081102
Liao C, Li Y, Tjong SC. Antibacterial Activities of Aliphatic Polyester Nanocomposites with Silver Nanoparticles and/or Graphene Oxide Sheets. Nanomaterials. 2019; 9(8):1102. https://doi.org/10.3390/nano9081102
Chicago/Turabian StyleLiao, Chengzhu, Yuchao Li, and Sie Chin Tjong. 2019. "Antibacterial Activities of Aliphatic Polyester Nanocomposites with Silver Nanoparticles and/or Graphene Oxide Sheets" Nanomaterials 9, no. 8: 1102. https://doi.org/10.3390/nano9081102
APA StyleLiao, C., Li, Y., & Tjong, S. C. (2019). Antibacterial Activities of Aliphatic Polyester Nanocomposites with Silver Nanoparticles and/or Graphene Oxide Sheets. Nanomaterials, 9(8), 1102. https://doi.org/10.3390/nano9081102

